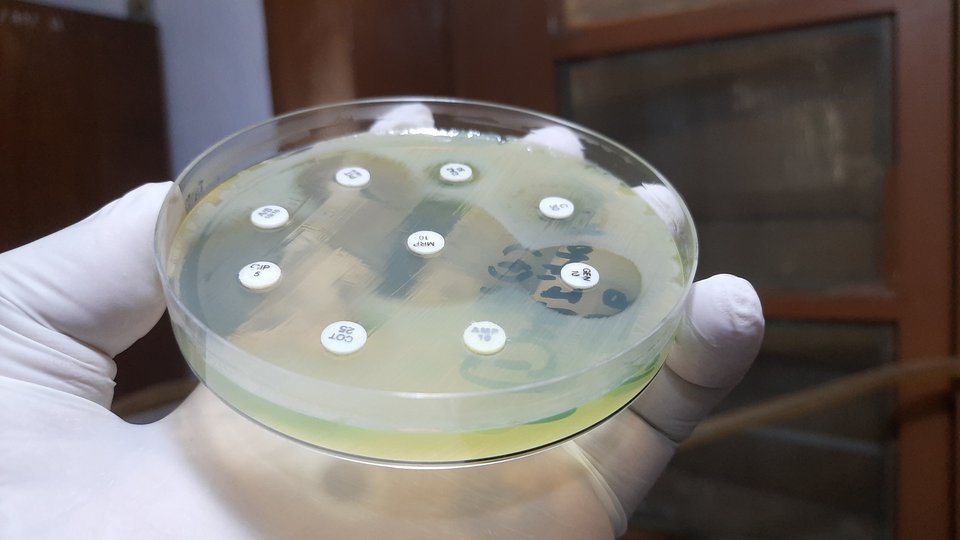

Um die Ausbreitung antibiotikaresistenter Bakterien zu bremsen, kommt es auf die rasche Diagnostik und den zielgerichteten Einsatz von Antibiotika an. Doch oft dauert die Überprüfung, welche Wirkstoffe bei einem Erreger noch wirken, mehrere Tage, weil Bakterien aus Patientenproben erst im Labor kultiviert werden müssen. Ein Team der Universität Basel, des Universitätsspitals Basel und der ETH Zürich hat eine Methode entwickelt, mit der sich Merkmale von Resistenzen mit Massenspektrometriedaten bereits 24 Stunden früher ermitteln lassen. Dabei suchen Computeralgorithmen in den Daten nach Mustern, die Bakterien mit und ohne Resistenz voneinander unterscheiden. Erschienen ist die Studie im Fachmagazin Nature Medicine.
Schon seit Jahren erscheint das VAA Magazin parallel zur gedruckten Ausgabe auch im PDF-Format sowie als interaktives E-Paper. Seit 2022 werden nun alle Artikel der aktuellen Ausgabe zusätzlich in Form eines Webmagazins auf www.vaa.de/vaamagazin veröffentlicht: Einfach rechts den Menüpunkt „Ausgabe Februar 2022“ anklicken – schon lassen sich die Artikel nach Rubrik sortiert aufrufen. Anders als das E-Paper eignet sich diese Art der Lektüre besonders gut fürs mobile Browsing über Smartphones und Tablets. Über die VAA-App lässt sich das Webmagazin ebenfalls lesen: Im Newsfeed links oben aufs Menü-Icon klicken, den Reiter „Der Verband“ wählen, anschließend rechts oben auf „+“ gehen und nach unten bis zur VAA-Magazin-Box scrollen. Fürs Webmagazin ist jedoch eher der direkte Weg über den Browser zu empfehlen. Wer das mittlerweile auf Recyclingpapier gedruckte VAA Magazin abbestellen möchte, um sich in den elektronischen Magazinverteiler aufnehmen zu lassen, kann dies per E-Mail an redaktion@vaa.de tun.

Für die Pflanzenzucht ist die Nutzung genetischer Information unerlässlich geworden. Doch deren Erhebung macht nach wie vor einen Großteil der Kosten aus. Diese lassen sich senken, indem nur ein sehr kleiner, zufällig ausgewählter Teil des Genoms sequenziert wird – die verbliebenen Lücken könnten mit mathematisch-statistischen Mitteln vervollständigt werden. Dafür hat ein interdisziplinäres Forschungsteam der Universität Göttingen einen neuen methodischen Ansatz zur Zucht von Maispflanzen mit geringer Anfälligkeit gegen Frost- und Dürreschäden entwickelt, der in der Fachzeitschrift PLOS Genetics veröffentlicht wurde. Kernidee des Verfahrens ist die Erkennung sogenannter Haplotypenblöcke – längerer Abschnitte im Genom – die in verschiedenen Pflanzen durch Vererbung sehr ähnlich sind, und Nutzung dieser Mosaikstruktur. In Zuchtpopulationen haben die so ergänzten Sequenzen eine Qualität, als sei ein Hundertfaches an Informationen des DNA-Strangs erhoben worden.
Vom 21. bis zum 24. August findet die nächste VAA-Pensionärsreise statt. Das Reiseziel ist Halle an der Saale. Weitere Details folgen im nächsten VAA Magazin.

Sowohl Thymian als auch Oregano sind beliebte Gewürzkräuter und Arzneipflanzen. Ihre ätherischen Öle enthalten die chemisch ähnlich aufgebauten Substanzen Thymol und Carvacrol, die für das typische Aroma sorgen. Beide besitzen zudem sekretlösende, antibakterielle und krampflösende Eigenschaften. Ein Team der Martin-Luther-Universität Halle-Wittenberg (MLU) und der Purdue University in den USA hat vor Kurzem lückenlos aufgeklärt, wie diese beiden Stoffe in den Pflanzen gebildet werden. Die Ergebnisse könnten dabei helfen, die Züchtung und pharmazeutische Nutzung beider Pflanzen zu verbessern. Die Studie ist in der Fachzeitschrift Proceedings of the National Academy of Sciences erschienen.
Aus den VAA-Werksgruppen gibt es einige Wechsel zu vermelden. So ist Dr. Anja Finke neue Vorsitzende der Werksgruppe Symrise. Einen neuen Vorstand hat die Werksgruppe Trostberg: Neben der neuen Vorsitzenden Dr. Anna Visser (Alzchem) gehören Dr. Sylvia Huber (Alzchem), Dr. Rainer Packe-Wirth (BASF Construction Additives) und Dr. Alois Maier (Master Builders Solutions Deutschland) zum Gremium der unternehmensübergreifenden Standortwerksgruppe. In der Werksgruppe Roche Penzberg ist Dr. Michael Linden zum neuen Vorsitzenden gewählt worden, Stellvertreterin bleibt Britta Moser. Zu den weiteren Vorstandsmitgliedern gehören wie bisher Dr. Christian Klaus, Dr. Klaus Riebel und Dr. Michael Knoll.

Was braucht es heutzutage für eine gute Führungskultur? Eine Atmosphäre des Mit- und Wohlfühlens auch am Arbeitsplatz, betonte die Autorin und Management-Trainerin Sabine Asgodom Anfang Dezember 2021 auf einer Onlineveranstaltung des Frauennetzwerks VAA connect. Über 100 Teilnehmerinnen und Teilnehmer haben von der Journalistin erfahren, welche Methoden zur Steigerung der Selbstmotivation es gibt. Führungskräfte könnten neuen Rahmen für Höchstleistungen schaffen, indem sie Beschäftigte und Teammitglieder besser erreichen und mitnehmen. Grundlage dessen sei Asgodom zufolge Achtsamkeit, gute Kommunikation und vor allem „Empathie statt Ellenbogen“ – so lautete auch der Titel der Veranstaltung. Eingeloggten VAA-Mitgliedern steht auf der Mitgliederplattform MeinVAA ein bereinigter Audiomitschnitt des Vortrags zur Verfügung.
Aufgrund der Nachfrage nach Informationen über die Geschäftslage der chemisch-pharmazeutischen Industrie bietet der Verband der Chemischen Industrie den „World Chemistry Report“ an. Dieser zeigt die aktuelle Produktionsentwicklung in den wichtigsten Ländern und Regionen sowie der Welt als Ganzes. Gemäß dem Januarbericht 2022 bleibt die Produktion zweigeteilt: Während die Pharmaproduktion ihren Aufwärtstrend weltweit fortsetzt, wächst die Chemieproduktion aufgrund der weiterhin fortdauernden Liefer- und Transportengpässe nur verhalten. Im monatlich erscheinenden Report veranschaulichen außerdem Grafiken die Trends in den vergangenen Jahren.

Bislang ist die Speicherung von Wasserstoff aufwendig: Entweder wird das Gas in Drucktanks bei bis zu 700 bar aufbewahrt oder aber in flüssiger Form, wobei es bis auf minus 253 Grad Celsius abgekühlt werden muss. Ein Forschungsteam des Deutschen Elektronen-Synchrotrons (DESY), der Universität zu Köln und der Universität Hamburg hat kürzlich die Grundlage für eine neue Methode erarbeitet: die Speicherung mit nur 1,2 Nanometer großen Teilchen aus Palladium. Stabilisiert werden die auf Graphen fixierten Nanoteilchen (in der Grafik grün) durch einen Kern aus Iridium (in der Grafik rot). Auf der Oberfläche der „Nanopralinen“ kann sich Wasserstoff wie eine Art Schokoladenglasur anlagern und durch Erwärmen wieder abgelöst werden. Veröffentlicht wurde die Studie im Fachblatt ACS Nano.
Anfang Februar 2022 sind die Fragebögen für die Einkommensumfrage versandt worden. Um die statistische Aussagekraft weiter zu steigern, bittet der VAA alle im Berufsleben stehenden Mitglieder, sich bis Ende März an der von der RWTH Aachen wissenschaftlich begleiteten Studie zu beteiligen. Die Umfrage liefert den umfangreichsten Überblick über die Gehaltsentwicklung bei Fach- und Führungskräften in der Chemie- und Pharmabranche. Sie bildet die Grundlage für den VAA-Gehalts-Check, der exklusiv für VAA-Mitglieder auf der Mitgliederplattform MeinVAA abrufbar ist.


Beim Darmstädter Wissenschafts- und Technologiekonzern Merck sind die Leitungspositionen von Global R&D und Strategy des Unternehmensbereichs Healthcare neu besetzt worden. Danny Bar-Zohar (im Bild) wurde zum globalen Leiter der Forschung & Entwicklung (F&E) und Jörn-Peter Halle zum Chief Strategy Officer ernannt. In seiner neuen Funktion ist Bar-Zohar auch für Medical Affairs verantwortlich. Er trat im November 2020 als Executive Vice President und Global Head of Development ins Unternehmen ein und verfügt über mehr als zehn Jahre Führungserfahrung in der Pharmabranche, unter anderem bei Novartis und Teva. Jörn-Peter Halle übernimmt als CSO auch die Leitung von Business Development. Er war in den vergangenen 18 Monaten als Executive Vice President und Global Head of Research für Merck tätig. Halle kam 2005 zu Merck und verfügt über mehr als 25 Jahre Branchenerfahrung. Sowohl Bar-Zohar als auch Halle werden weiterhin dem Healthcare Executive Committee angehören und ihre Aufgaben von der Konzernzentrale in Darmstadt aus wahrnehmen.
Wie steht es um das Engagement von Unternehmen und Organisationen in Deutschland für ihre lesbischen, schwulen, bisexuellen, trans- und intergeschlechtlichen sowie queeren Beschäftigten? Dazu hat die Uhlala Group im Dezember 2021 ihren PRIDE Index 2021 veröffentlicht, der Erfolge des Diversity Managements im Bereich LGBTIQ+ aufzeigt und Potenziale zur Weiterentwicklung identifiziert. Angeführt wird der Index von der Allianz, SAP und McKinsey. Als Vertreter der Chemie- und Pharmabranche kommen Pfizer auf den fünften und Bayer auf den siebten Rang. Insgesamt zeige sich der Uhlala Group zufolge, dass Unternehmen, die in einem starken Wettbewerb um Talente stehen, sich besonders für LGBTIQ+ einsetzen. Für LGBTIQ+-Nachwuchstalente sei das inklusive Umfeld potenzieller Arbeitgeber oftmals wichtiger als das Einstiegsgehalt, belegen auch verschiedene Diversity-Studien.

Aus natürlich vorkommenden Nukleobasen, die genetische Informationen zu DNA und RNA kodieren, werden sogenannte Thiobasen gewonnen. Diese Klasse von Molekülen eignet sich für eine Vielzahl medizinischer Anwendungen, einschließlich neuer Krebstherapien. Ein internationales Forschungsteam unter Leitung der Universität Potsdam hat kürzlich Ladungsbewegungen in lichtangeregten Molekülen der modifizierten Nukleobase Thiouracil beobachtet und den Mechanismus erhellt, warum Thiobasen in potenziell schädliche Zustände übergehen. Die Ergebnisse der am Deutschen Elektronen-Synchrotron (DESY) durchgeführten Laserexperimente wurden im Journal Nature Communications publiziert und eröffnen neue Möglichkeiten, die Ladungsflüsse innerhalb der Moleküllandschaft zu kartieren.
Um Engpässe bei der arbeitsmedizinischen Versorgung zu evaluieren und Modelle für eine Optimierung zu entwickeln, hat die Bundesärztekammer gemeinsam mit der Deutschen Gesellschaft für Arbeits- und Umweltmedizin und dem Verband Deutscher Betriebs- und Werksärzte die „Task Force Arbeitsmedizin“ gebildet. Erste Ergebnisse sind kürzlich in einem Konzeptpapier zusammengefasst worden.

Sowohl bei der Energiezufuhr für Zellen als auch bei der Abwehr von Krankheitserregern spielen Mitochondrien eine Schlüsselrolle. Die winzigen Zellkraftwerke können Immunreaktionen auslösen und Erregern ihre für das Wachstum benötigten Nährstoffe entziehen. Ein Forschungsteam des Max-Planck-Instituts für Biologie des Alterns in Köln und der Universität Bonn hat vor Kurzem gezeigt, dass Krankheitserreger die mitochondrialen Abwehrmechanismen ausschalten können, indem sie eine normale zelluläre Reaktion auf Stress aushebeln. Im Bild wird gezeigt, wie der Parasit Toxoplasma gondii (rot) die Mitochondrien (grün) dazu bringt, große Strukturen ihrer „Haut“ (gelb) abzustoßen. Erschienen ist die Studie in der Fachzeitschrift Science. Ein Video dazu ist bei YouTube eingestellt.